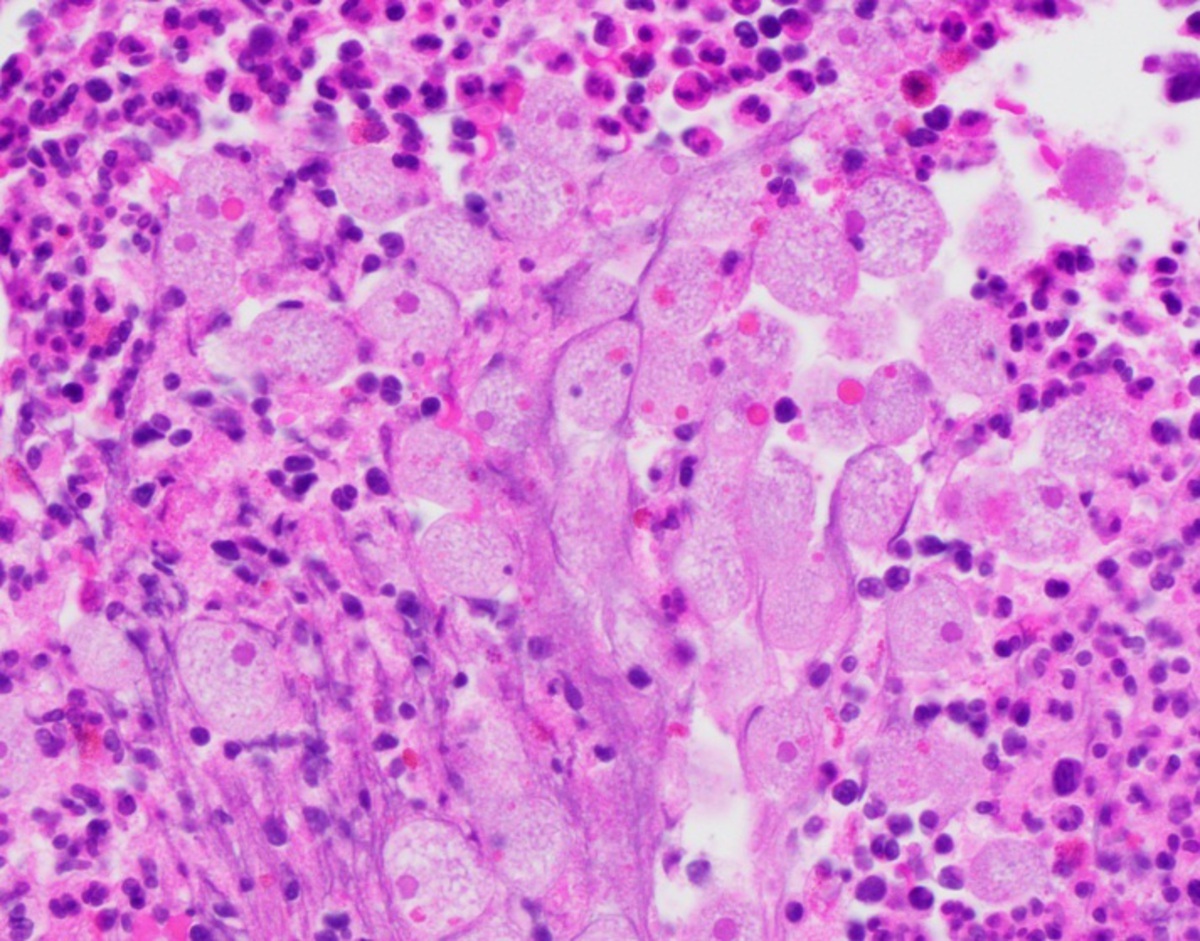
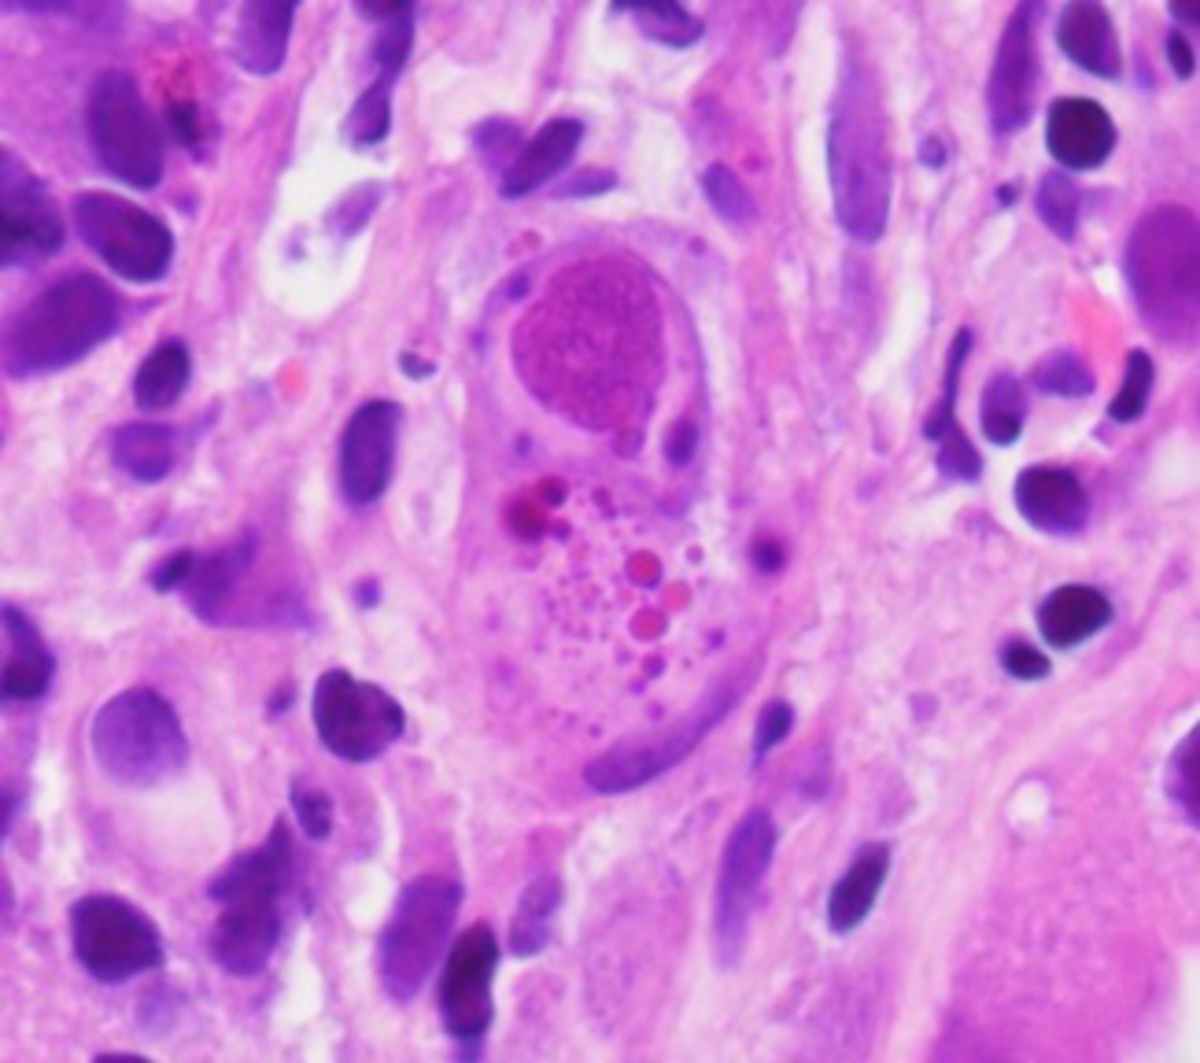

60F rectal bleeding began 1 year ago. Dx initially w/ hemorrhoids 3mo prior w/ PCP gave her hydrocortisone suppositories,no improvement. DRE with picture, hard, tender, 2-cm mass at the posterior anal verge. What is the next step?
A. Start the patient on imiquimod 5% for treatment of peri-anal condylomatosis.
B. Refer the patient to a colorectal surgeon for an abdominoperineal resection.
C. Check carcinoembryonic antigen (CEA) and refer to an oncologist for treatment of rectal cancer.
D. Refer the patient to a colorectal surgeon for evaluation and biopsy.

- squamous cell carcinoma of the anus (SCCA)
- definitive diagnosis>surgeon for biopsy.
- lesion seen is typical for SCCA not condylomata - Imiquimod for the treatment of external genital and anal condylomata
- Answer B is incorrect because abdominoperineal resection is not the first-line treatment
53 M w/ FAP- EGD Six white lesions ranging in sizes from 1-3 mm in duodenum. Papilla normal. Tubular adenomas on biopsy. What is the next step?
A. Repeat EGD in 3-6 months.
B. Repeat EGD in 1 year.
C. Repeat EGD in 2-3 years.
D. Refer to a surgeon.
- EGD surveillance FAP for duodenal adenomas/inc cancer R
- polyp size, number, histology and degree of dysplasia. This patient has SS II duodenal polyposis. The 10-year cumulative risk of duodenal cancer with this stage is 2.3%.
- Guidelines suggest repeat EGD and assessment of the papilla in 2-3 years for this SS.
- Individuals with SS IV polyposis should be referred to an expert center for EGD every 3-6 months or to a surgeon for consideration of prophylactic duodenectomy
42M excruciating perianal pain.3:00 AM and woke him from sleep. Large “purple bulge” emanating from his anal verge. next best step in the management?
A. Surgical excision of the blood clot
B. Intravenous hydromorphone
C. Phenylephrine gel
D. Anal sphincterotomy
E. Topical lidocaine

- This is an image of a thrombosed external hemorrhoid. These usually present with acute onset of severe pain due to the formation of a clot in the vascular tissue.
- If a patient presents within 72-96 hours of the pain onset, definitive treatment and pain resolution will occur after surgical excision of the clot with removal of the overlying skin. The latter portion of this intervention prevents recurrence.
- IV hydromorphone- temp, not definitive solution.
- Phenylephrine gel is more effective in the treatment of acute symptoms of internal hemorrhoids and also will not provide definitive results.
- Anal sphincterotomy is a treatment for chronic anal fissures, not a thrombosed external hemorrhoid.
- Topical lidocaine will only provide short-term temporary relief.
59F w/ AML achieved clinical remission after chemotherapy and allogenic stem cell transplant 6 months ago. PMH HTN/hypothyroidism. ED w/ explosive nonbloody diarrhea 4-5 times daily for over 1 week. She also reports lower abdominal bloating but no nausea, vomiting, fevers, or chills. She took bismuth subsalicylate which turned her stools dark. She has no recent history of travel, eating outside, or sick contact. She was treated with a 7-day course of ciprofloxacin for urinary tract infection about 1 month ago by her primary care physician. On arrival, she was febrile to 103°F, heart rate 102 beats per minute, blood pressure 120/65, respiratory rate 16/minute, and oxygen saturation of 96% on room air.
Aspergillus and beta-glucan levels, CMV PCR, and EBV PCR were sent to the laboratory. A chest radiograph was unremarkable. She was started on empiric antibiotics-cefepime, metronidazole, and vancomycin. The gastroenterology team was consulted. Colonoscopy showed severe colitis involving the left side of the colon as shown in the figure. Histopathology showed focal rare apoptotic crypt epithelial cells along with active colitis with ulceration. What is the most likely diagnosis?
A. CMV colitis
B. Clostridioides difficile colitis
C. Graft-versus-host disease (GVHD)
D. Ischemic colitis

- GVHD is a complication of allogeneic hemopoietic stem cell transplant. It affects multiple systems, including skin, liver, and gastrointestinal tract.
- GVHD is categorized as acute or chronic based on onset using 100 days cut off from transplant.
- immune reaction of retained donor’s leukocytes in the transplanted tissue against the recipient’s tissue(s)
- Treatment of GVHD involves using steroids to suppress host T cell-mediated immune response.
- CMV colitis immunosuppressed patients also like this one but w/ characteristic intranuclear inclusions with “owl’s eye”
32M hx depression w/ rectal pain & BRBPR. Recent dx IBS, with longstanding, mild symptoms characterized by intermittent, urgent loose stools associated with abdominal pain, especially under periods of stress. Dx external hemorrhoids by PCP 1y ago. Now rectal bleeding and worsening rectal discomfort. His social history is notable for receptive anal intercourse. He received the HPV vaccine at the age of 26.Exam posterior midline lesion, extremely tender to the touch. next?
A. Referral to colorectal surgery for possible surgical treatment
B. Rectal biopsies and urine collection for nucleic acid amplification test (NAAT)
C. Colonoscopy for evaluation of possible inflammatory bowel disease
D. Frequent warm sitz baths, stool softeners, and a high-fiber diet

- Anal fissure- 90% posterior midline, as this area is subjected to the highest forces during defecation, has weaker supporting musculature, and likely poor blood flow relative to the rest of the sphincter complex to promote healing.
- These atypical fissures can occur in patients with anorectal carcinoma, Crohn’s disease, immunodeficiency syndromes such as AIDS, tuberculosis, and a number of sexually transmitted diseases.
- Although the history of receptive anal intercourse should raise suspicion for anorectal carcinoma, the patient received the HPV vaccine (decreasing his risk of anal cancer via HPV), and the fissure has a typical appearance.
- Similarly, NAAT testing for chlamydia, a cause of the STI lymphogranuloma venereum (LGV), a variant of Chlamydia trachomatis that can manifest with anorectal symptoms in men who have sex with men, is less likely with a typical fissure morphology.
- In a typical fissure, the likelihood of Crohn’s disease is low, so colonoscopy would be unnecessary at this stage.
- The presence of visible muscle fibers in this fissure suggests a degree of chronicity that may not respond to conservative treatments; nevertheless, a trial of warm sitz baths, stool softeners, and a high-fiber diet is warranted before moving forward with surgical referral for possible sphincterotomy.
A 55-year-old female smoker with no significant past medical history presents with left lower quadrant abdominal pain over the last 3 months. She has had recent constipation with intermittent rectal bleeding and notes that her pain is worse with bowel movements. She has never had a colonoscopy. On exam, she is afebrile and has mild left and right lower quadrant tenderness to palpation with mild guarding and no rebound. During colonoscopy, her Boston bowel prep score is 3 and visualization is difficult. She has distal sigmoid edema and narrowing which cannot be traversed despite multiple attempts. A biopsy of the sigmoid colon is shown in the figure. The scope is withdrawn and in recovery, the patient has worsening abdominal pain. What should you do next?
A. Send her home with a clear liquid diet and tell her the pain will get better after she passes gas.
B. Contact a surgeon because this patient has a malignant stricture and needs surgery right away.
C. Get an abdominal CT scan to rule out perforation related to diverticulitis.
D. Perform an upper endoscopy to evaluate the pain.
E. Give the patient a laxative and perform another colonoscopy in a few weeks.

This patient has classic findings of diverticulitis. Up to 15% of patients with diverticulosis develop diverticulitis. Tobacco use is an independent risk factor of diverticulitis. Diverticulitis is a micro or macro perforation of a diverticulum. A subset of patients develop smoldering diverticulitis and can have subacute prolonged symptoms of abdominal pain, rectal bleeding, and change in bowel habits that can last over 6 months. Abdominal imaging, preferably computed tomography (CT) scan, should be obtained to establish the diagnosis of acute diverticulitis. The patient should not be sent home without a confirmed diagnosis and the extent of diverticulitis needs to be established before treatment is given. Colonoscopy should be performed after complete resolution of diverticulitis, typically after 6-8 weeks if the patient has not had a colonoscopy in the last year to rule out a malignant process. Colonoscopy should not be performed prior to recovery from acute or subacute diverticulitis because of higher risk of perforation during this inflammatory state.
The pathology slides demonstrated acutely inflamed colonic mucosa in an area of diverticulitis. There are glands with acute (neutrophils) and chronic (lymphocytes and plasma cells) inflammation inside and around the glands. The pathology slide demonstrates microabscess with numerous eosinophils >15/HPF.
64F hx class 3 obesity (body mass index ≥40 kg/m2) and irritable bowel syndrome presents for treatment of her chronic posterior anal fissure which has been present for the past year. She has been treated with bulking agents, soluble fiber, sitz baths, 0.3% topical nifedipine compounded with 2% lidocaine, 0.2% topical nitroglycerin, and oral nifedipine 20 mg daily without relief. She is afraid to have a bowel movement and, in many circumstances, voluntarily retains stool because it is just too painful to defecate. She admits that this has ruined her quality of life. She is tearful and begging for an alternative form of relief. She previously experienced 3 traumatic vaginal births. Figure. Which of the following would be the next most appropriate course of therapy?
A. Oral diltiazem - already tried Nifedipine
B. Lateral internal sphincterotomy (LIS)
C. Anal fissurectomy
D. Botulinum toxin A injection
E. Anal sphincteroplasty - for FI, not fissures

- chronic posterior anal fissure
- multiple local/oral therapies ineffective
- multiple children-disruption/tearing of the anal sphincters
- Furthermore, she has other risk factors for developing fecal incontinence including irritable bowel syndrome and class 3 obesity.
- sphincteroplasty NOT for anal fissures. Later-stage tx for FI
- Lateral internal sphincterotomy and anal fissurectomy are primary surgical interventions recommended for the treatment of nonhealing chronic anal fissures but are usually deferred in individuals with higher risks of fecal incontinence until a trial of botulinum toxin has been completed.
- botulinum toxin injection
- significantly lower rates of fecal incontinence than the lateral internal sphincterotomy
A 40-year-old man presents to discuss treatment for his hemorrhoids. He has been consuming 25 grams of soluble fiber a day and soaking in sitz baths 3 times a day. He previously used topical phenylephrine gel and witch hazel but neither has afforded any relief. During the past month, he has been using hydrocortisone 2.5% suppositories but continues to experience daily pruritis ani and bleeding. On exam, you have him bear down and the changes seen in the figure are witnessed at the anal verge. Despite waiting, there is no evidence of spontaneous regression, but these can be reduced manually. Based on these findings, what is the best next course of action?
A. Stapled hemorrhoidopexy
B. Hemorrhoidectomy
C. Rubber band ligation
D. Infrared coagulation
E. Sclerotherapy

- The history and physical exam are consistent with grade 3 hemorrhoids (prolapse but must be manually reduced). This patient has tried using fiber and other local treatments including steroids. In this situation, rubber band ligation, infrared coagulation, and sclerotherapy can all be considered, but rubber band ligation has been associated with decreased need for repeat therapy and fewer side effects. Stapled hemorrhoidopexy has fallen out of favor due to increased risks of side effects and recurrence rates. Hemorrhoidectomies are usually reserved for those refractory to less invasive maneuvers or grade 4 hemorrhoids.
22F heathy but w/ constipation dating back at least to her teens. She describes infrequent, hard bowel movements occurring approximately 4 times per week with straining and a sense of anorectal blockage. Brown stool in the rectal vault. Tried psyllium and polyethylene glycol without benefit. Because she has failed conservative measures, you perform an anorectal manometry. What course of action would be recommended next?
A. Treat with a secretagogue or prokinetic agent
B. Referral for pelvic floor biofeedback therapy
C. Colonoscopy
D. Studies to assess colonic transit

- In a patient who has failed conservative treatment with over-the-counter laxatives and fiber supplementation
- DO arm W/ bet
- Although the balloon expulsion results are not given the pictured tracing shows an adequate increase in rectal propulsive pressure with a paradoxical contraction of the muscles of the anal canal suggestive of dyssynergic defecation.
- prompt referral for biofeedback therapy.
- treatment with a secretagogue or prokinetic only after anorectal manometry has been performed and found to be normal.
- If anorectal manometry is normal and a trial of a secretagogue or prokinetic is ineffective, colonic transit testing may be used to confirm slow-transit constipation, but keep in mind that many patients with disordered defecation will have evidence of delayed colonic transit.
- Colonoscopy rarely indicated in constipation
- received age-appropriate cancer screening and
- not reporting alarm symptoms
49m colonoscopy for chronic abdominal pain and chronic diarrhea. intermittent watery diarrhea symptoms associated with severe right lower abdominal cramping pain recurring on and off for the past year. Worsening. No blood. PMH chronic LBP takes ibuprofen on an as-needed basis. While he has not traveled much during the past year due to the COVID-19 pandemic, he previously traveled extensively for work, particularly to Central and South America. CBC/CMP wnl. CDI stool NEG. Several scattered mucosal ulcerations were seen on colonoscopy, particularly in the right colon [figures A and B]. Biopsies [figure C]. best next step?
A. Order CT scan of chest/abdomen/pelvis and referral to colorectal surgery.
B. Order CT angiogram of the abdomen and pelvis.
C. Start the patient on metronidazole followed by paromomycin.
D. Start the patient on infliximab with azathioprine.
E. Start the patient on oral vancomycin.

- The biopsies of the colon ulcers demonstrated findings on histology consistent with Entamoeba histolytica
- Tx of invasive colitis secondary to Entamoeba histolytica includes a 7-10 day course of metronidazole or tinidazole followed by a luminal agent such as aromomycin, iodoquinol, or diloxanide furoate.
- Biopsies not adenoCA - no CT/surg
- While the location of involvement is consistent with the pattern of injury seen in isolated right colonic ischemia, the histology is not consistent with ischemic colitis- no CTA
- Colon/histo - not IBD or CDI
25M intermittent blood mixed in with his stools. cscope- Moderate sigmoid diverticulosis. The 1-2-cm polyp with overlying erythema in the sigmoid colon. Histopathology from the polyp shows fibromuscular hyperplasia of the lamina propria, extension of the muscularis mucosa into the lamina propria and crypt elongation. There is no dysplasia. Staining is negative for smooth muscle actin, desmin, and c-KIT (CD 117).
A. Inflammatory pseudopolyp
B. Inflammatory polyp, prolapse type
C. Gastrointestinal stromal tumor (GIST)
D. Leiomyoma

- Prolapse type inflammatory polyps
- diverticular disease
- can display visible inflammation and ulceration
- from traction, distorsion, and twisting of mucosa from peristalsis-induced trauma
- Histopathology
- fibromuscular hyperplasia of the lamina propria, extension of muscularis mucosa into the lamina propria and crypt elongation
- Inflammatory pseudopolyps - irregularly shaped islands of intact colonic mucosa that occur in response to diffuse inflammation like IBD
- GIST- spindle cell tumors and are c-KIT (CD117) positive
- Leiomyomas typically found in the esophagus
- neg c-KIT
- positive for smooth muscle actin and desmin
48m 1 wk diarrhea with 10-15 BM/day + intermittent, diffuse abdominal pain and denies fevers. pmh kidney transplant 6 months prior hx dm1. His immunosuppression consists of tacrolimus and mycophenolic acid. No abx, travel, or sickC. CT scan reveals right colonic wall thickening centered at the hepatic flexure with surrounding mesenteric stranding. Colonoscopy scattered erosions with surrounding erythema and edema [figure A] worse in the proximal colon. TI normal. Colon biopsies active inflammation with abnormalities in the lamina propria [figure B]. pathogen?
A. Cryptosporidium parvum
B. Mycobacterium tuberculosis
C. Cryptococcus neoformans
D. Entamoeba histolytica
E. Cytomegalovirus
- colitis-associated with intracytoplasmic inclusions, as seen in the second image, is characteristic of cytomegalovirus (CMV) infection.
- Cryptosporidium of the small intestine can lead to malabsorption but does not manifest as colitis.
- Entamoeba involving the colon characteristically shows flask-shaped ulcers and/or trophozoites on biopsy.
- Intestinal tuberculosis generally involves the ileocecal region associated with systemic symptoms, and necrotizing granulomas can be seen on biopsies.
- Cryptococcal infection most commonly affects the central nervous system or lungs. It occasionally manifests gastrointestinal symptoms but is not consistent with colitis with intracellular inclusions.
A 46-year-old woman with obesity and a history of migraines, asthma, and anxiety presents to the emergency department (ED) with abdominal pain. She reports intermittent abdominal pain for approximately 6 months and has visited several other EDs during these episodes. She reports that last week she was in another ED and was told that she had some inflammation in a small area of her small bowel. She now states that the pains are as severe as last week, rated as 8/10 intensity, but more diffuse. The week prior, the pains were focused in her peri-umbilical area. She reports feeling constipated and has not had a bowel movement in 48 hours. On physical examination, she has some abdominal tenderness without rebound or guarding. Her only medication is an oral contraceptive pill.
Her serologic assessment shows:
WBC 20,600/µL (normal: 4,000-10,000/µL)
Hemoglobin 12.8 g/dL (normal: 12-16 g/dL)
Platelets 425,000/µL (normal: 150,000-350,000/µL)
Sodium 136 meq/L (normal: 136-145 meq/L)
Potassium 4.2 meq/L (normal: 3.5-5.0 meq/L)
Chloride 96 meq/L (normal: 98-106 meq/L)
Bicarbonate 18 meq/L (normal: 23-28 meq/L)
Blood urea nitrogen 16 mg/dL (normal: 8-20 mg/dL)
Serum creatinine 0.8 mg/dL (normal: 0.7-1.3 mg/dL)
An abdominal x-ray is performed, and the results are shown in the figure. The ED calls and asks what you think the next most important step would be for this patient?
A. Right upper quadrant ultrasound with Doppler
B. Obtain a CT angiogram.
C. Call interventional radiology to discuss angiography.
D. Call general surgery for emergency laparotomy.
E. Perform a rapid preparation for colonoscopy.

This patient is presenting with intermittent abdominal pains for several months in the setting of obesity and an oral contraceptive pill, both of which are risk factors for thrombotic processes. In addition, she reports that she has been to the ED intermittently and the week prior had an episode of enteritis. This is most consistent with a focal segmental ischemia that is evolving into an acute mesenteric ischemia from an atherosclerotic plaque in a branch of the superior mesenteric artery (SMA) that has now thrombosed. The modern classification for this is mesenteric arterial occlusive disease. The abdominal x-ray shows “thumbprinting” in the small bowel, a sign of mesenteric ischemia, along with dilations of the small bowel, consistent with development of an ileus. An ileus can also be seen in the setting of mesenteric ischemia. When a patient has a suspected mesenteric ischemia and if the ED has obtained a CT of the abdomen and pelvis, a call to the radiologist to review the images to ensure adequate visualization of the SMA is the most efficient next step to assess for patency and triage what should be done next. If the radiologist is unable to see the SMA and its branches, then consideration should be made for obtaining a CT angiogram. Of these next steps listed, a CT angiogram is the best option. A call to interventional radiology for angiography and presumably intervention is likely premature at this time as is obtaining a surgical consult, although surgery should be notified fairly rapidly when the diagnosis of acute mesenteric ischemia is obtained. A rapid colonoscopy would be the wrong step for this patient, and she would likely not survive the bowel preparation. An ultrasound with Doppler would not be helpful in this case.
45M rectal pain and bleeding for a year. w/ BM “cutting” sensation. Once the stool has passed, he experiences persistent throbbing pain over the subsequent 45 minutes before the pain spontaneously resolves. +TP blood. He was evaluated by another gastroenterologist approximately 3 months after his symptoms started and was found to have a chronic anterior fissure. CBC wnl, scope scattered diverticulosis in the sigmoid colon and a 2-mm ascending colon sessile serrated polyp. Initially, he admitted to symptoms of constipation (straining and incomplete evacuation) but those resolved with the addition of a soluble fiber supplement which he continues to use. He is frustrated because he has tried sitz baths with Epsom salts, topical nifedipine and nitroglycerin, oral diltiazem and none of these have proven effective. He does not report any associated history of fecal incontinence. next step in his care?
A. CT enterography to evaluate for evidence of Crohn’s disease -not atypical fiss, no other crohns s/s, not needed
B. Oral nifedipine 20 mg twice a day
C. Botulinum toxin (20 units) injected on either side of the anal fissure - If FI
D. Fissurectomy - if FI
E. Lateral internal sphincterotomy
- medically refractory chronic anal fissure
- anterior midline fiss less common 25% and 8% of W/M
- not consider atypical (lateral are- STD/TB/lymphoma/Crohn’s disease)
- oral nifedipine - little evidence, tried and failed to respond to multiple topical and oral therapies.
- Botox and anal fissurectomies- for history of or multiple risk factors for fecal incontinence
- If no FI- lateral internal sphincterotomy
- head-to-head trials with topical and oral agents, botulinum toxin, fissurectomy, lateral internal sphincterotomy >>>>> symptomatic relief with healing 95% of patients- inc FI risk
A 62-year-old man with a history of hypertension, coronary artery disease following stent placement 2 years ago, and chronic obstructive pulmonary disease presents to the emergency department with acute onset of abdominal pain. He takes clopidogrel and lisinopril. His pain is described as a 9/10 on the right side and a sharp band throughout his abdomen. He has watery diarrhea that started when the pain began. He has had 3 bowel movements since the onset of his symptoms and undergoes an initial x-ray [figure]. What is the best next step in the management of this patient?
A. Computed tomography (CT) of the abdomen and pelvis
B. Call surgery for an emergency laparotomy
C. Computed tomography (CT) of the abdomen and pelvis with angiography
D. Right upper quadrant sonogram

The x-ray shows pneumatosis linearis lining the right colon. In this circumstance, there is a concern for isolated right colon ischemia and possibly concomitant acute mesenteric ischemia. The most critical next test is an angiographic study to delineate how best to treat the patient. CT of the abdomen and pelvis alone might miss a vascular obstruction that requires immediate interventional radiology or vascular surgical intervention. Calling surgery for an emergency laparotomy might be best if there was clear evidence of a perforated viscus. Still, in this case, vascular imaging is most important because that will triage how to approach the patient most effectively. If there is a thrombus or embolus in the SMA, this will also reveal the distribution and whether the small bowel might be involved. Also, with a known vascular obstruction, an endovascular followed by a surgical approach might be optimal. If there is no clear vascular obstruction, then going straight to the operating room might be optimal. It is doubtful that this patient has a biliary process, so obtaining a right upper quadrant sonogram would not target the underlying diagnosis and delay identifying this acute situation.
58F FIT+>C scope: 30 lesions identified proximal to the splenic flexure, of which 7-10 are larger than 1 cm with most of these polyps appearing serrated by endoscopic criteria. No AO polyps. Additionally, more than 20 lesions, also appearing serrated by endoscopic evaluation, are identified in the rectosigmoid, none appear larger than 1 cm. What is the best and safest treatment approach for this patient?
A. Subtotal colectomy followed by endoscopic clearance of the rectum or rectum and distal sigmoid
B. Endoscopic submucosal dissection (ESD) of the large proximal colon lesions, followed by cold snare polypectomy of the remaining lesions
C. Hot endoscopic mucosal resection (EMR) of the larger proximal colon lesions, followed by cold snare polypectomy of the remaining lesions
D. Cold EMR of the large lesions, followed by cold snare polypectomy of the remaining lesions
- This patient has serrated polyposis syndrome (SPS) and fulfills the criteria for both type 1 and type II SPS if the pathological examination confirms SSL.
- SP
- cold EMR for large lesions, though cold piecemeal resection may be similarly effective
- Endoscopic clearance of this number of lesions can usually be completed over 1-2 extended colonoscopies.
- Surgery is indicated when unable to control polyp growth endoscopically.
Biopsy findings of SRUS
smooth muscle hyperplasia in the lamina propia between colonic glands, and surface ulceration with associated chronic inflammatory infiltrates
Which of the following caused by HPV type 16?
A. Squamous cell carcinoma of the anus
C. Condyloma in the anal canal - low risk HPV HPV-6 and HPV-11
D. Low-grade squamous intraepithelial lesion (LSIL) of the anus - low risk HPV
- Approximately 90% of squamous cell carcinoma of the anus (SCCA) is associated with high-risk HPV, most commonly types 16 and 18
- Greater than 50% of SCCA are caused by HPV-16
Treatment of C diff
first
second
first - vanc
2nd- vanc taper or fidoxmicin
3rd occurence (2nd recurrence) FMT = 3
- We recommend FMT be delivered through colonoscopy or capsules, enema if other methods are unavailable
- We suggest repeat FMT for patients experiencing a recurrence of CDI within 8 weeks of an initial FMT
- For patients with rCDI who are not candidates for FMT, who relapsed after FMT, or who require ongoing or frequent courses of antibiotics, long-term suppressive oral vancomycin may be used to prevent further recurrences
- Oral vancomycin prophylaxis (OVP) may be considered during subsequent systemic antibiotic use in patients with a history of CDI who are at high risk of recurrence to prevent further recurrence (conditional recommendation, low quality of evidence).
45M w/ HIV diagnosed at age 29 here for chronic GERD. CD4 79 on dx (normal range: 500-1,200 cells/mm3) started HAART. No anal pain or rectal bleeding. He is currently sexually active with his long-term male partner. CD$ 950, VL undetectable. What would you offer for anal high-grade squamous intraepithelial lesion (HSIL) screening?
A. Do not offer screening; his risk for anal cancer is low. -pt high risk for anal cancer
B. Perform a flexible sigmoidoscopy.
C. Perform a digital anorectal examination with anal cytology.
D. Perform a colonoscopy.
- HIV+ MSM most likely to benefit from a digital ano-rectal examination, anal cytology and if possible, high resolution anoscopy.
- Lower nadir CD4 T lymphocyte count is also a risk factor for squamous cell carcinoma of the anus.
- Answers B and D are incorrect because anal lesions are commonly missed on flexible sigmoidoscopy and colonoscopy.
- Endoscopes lack the proper magnification for small, flat lesions and do not sufficiently splay the tissue of the anal canal.
- These examinations are not typically performed with the vital stains used in high-resolution anoscopy: acetic acid 5% and Lugol’s solution.
43M HTN/COPD- abdominal pain and bloody diarrhea. Over the last week, he describes having a sore throat, runny nose, and cough. For these symptoms, he started taking pseudoephedrine. He reported eating chicken about 2 hours prior to presenting to the ED, and recalls a history of food poisoning due to undercooked food.
In the ED, he describes acute onset of cramping, peri-umbilical and left upper quadrant pain beginning 6 hours ago, rated 7 out of a scale of 10, lasting 15-30 minutes followed by numerous bloody bowel movements including blood clots. He is currently hemodynamically stable and notes improvement in his abdominal pain. His serologic assessment shows a normal complete blood count, electrolytes, and liver tests. What is the best next test to diagnose this patient’s condition?
A. CT scan of the abdomen and pelvis with oral and IV contrast
B. Colonoscopy
C. Flexible sigmoidoscopy
D. Stool culture
E. Stool ova and parasites
- This patient is presenting with a classic case of ischemic colitis which was likely induced by the usage of pseudoephedrine for his viral upper respiratory tract infection.
- colonic ischemia
- Men>>>>>>women
- COPD is a major risk factor
- Left upper quadrant and peri-umbilical pains so the distribution is most likely the descending and/or sigmoid colon. This is the most common distribution for this disorder.
- CT scan of the abdomen and pelvis would be most helpful to assess for colitis/localize the distribution.
- If there is a segmental colitis in the same distribution as the pain, then this is clinically diagnostic for colonic ischemia.
The patient did note a history of a similar presentation several months earlier in the setting of eating chicken. With that episode, he might have had Campylobacter jejuni infection. The timing of this infection with relation to the meal argues against this etiology again as Campylobacter jejuni typically requires 1 to 7 days of incubation prior to symptomatic presentation and most commonly presents with profuse watery and/or bloody diarrhea. Given this, a stool culture is less likely to be helpful in the diagnosis of this patient.
- Stool ova and parasite is most commonly helpful in patients presenting with nonbloody diarrhea.
- Colonoscopy and flexible sigmoidoscopy would be premature to perform given the clinical presentation.
48M Cscope, +FH CRC. At colonoscopy, a 50-mm granular, lateral-spreading lesion is identified in the proximal ascending colon. The lesion occupies approximately one-third of the luminal circumference and extends over 2 haustral folds. Postprocedure, the findings are discussed and the patient is referred to a regional center for endoscopic resection. At the regional center, the patient undergoes hot piecemeal endoscopic mucosal resection (EMR). At the end of snare resection, there is no evidence of residual polyp. Which of the following best describes the evidence-based steps that should take place next?
A. Clip closure of the EMR defect, followed by repeat colonoscopy in 6 months
B. Snare tip soft coagulation treatment of the margins, followed by clip closure if feasible, followed by repeat colonoscopy in 6 months
C. Snare resection of the margins, followed by clip closure if feasible, followed by repeat colonoscopy in 6 months
D. Snare tip soft coagulation treatment of the margins, followed by coagulation of all exposed blood vessels in the base of the EMR defect, followed by clip closure if feasible, followed by repeat colonoscopy in 6 months
- After piecemeal EMR utilizing electrocautery, the standard treatment to reduce recurrence is
- snare tip SOFT COAGULATION treatment of the normal-appearing mucosa at the margin
- The criteria for prophylactic clip closure to reduce delayed hemorrhage
- size ≥20 mm
- location proximal to the splenic flexure, and
- resection using electrocautery
- RCTs w/ coagulation forceps have not shown a benefit for coagulation of exposed vessels in the EMR defect.
68F Cscope - 7 adenomas are removed, the largest of which is a pedunculated polyp at 30 cm in the sigmoid colon s/p en bloc w/ clip on the residual stalk. Path- well-differentiated adenoCA invading the stalk and extending to a distance of .5 mm from the resection line. There is no lymphovascular invasion. CEA wnl, CT CAP IV contrast no disease. Which most appropriate?
A. Surgical resection of the sigmoid colon
B. Repeat colonoscopy in 3 years
C. Repeat colonoscopy in 6-12 months
D. Repeat colonoscopy now
- pedunculated colorectal polyp w/ cancer, histologic features that are considered unfavorable and favor surgical resection
- poor differentiation
- lymphovascular invasion, and
- tumor encroaching on the resection margin, or
- within 1 mm of the resection margin
- In this case, all the histologic criteria are favorable.
- Under these circumstances, the risk of residual cancer in the bowel wall or lymph nodes is very low but not zero.
- The risks of residual cancer and the risks of surgical resection should be reviewed with the patient, and a recommendation regarding surgery can be made, but the patient’s wishes should also be considered in reaching a final decision regarding adjuvant surgical treatment.
- Most patients with residual disease have cancer in the lymph nodes rather than the bowel wall.
- Thus, removal of the resection site using the full-thickness resection device cannot effectively eliminate the possibility of a lymph node metastasis and is not warranted in this instance.
A 50-year-old woman with no family history of colon cancer or advanced adenomas has an index screening colonoscopy. This exam finds a 1.5-cm descending colon polyp, removed with a cold snare. Pathology shows tubular adenoma. Subsequent high-quality surveillance colonoscopies at age 53 and 58 do not show any polyps. What is the next appropriate step in her colon cancer surveillance regimen?
A. Colonoscopy at age 61 (3 years)
B. Colonoscopy at age 63 (5 years)
C. Colonoscopy at age 68 (10 years)
D. Yearly FIT testing beginning at age 68 (10 years)
- In the 2020 USMSTF surveillance guidelines, an advanced adenoma mandates a 3-year follow-up, with next colonoscopy occurring another 5 years later, assuming no higher risk findings at the second colonoscopy shorten the interval.
- Unlike the previous 2012 USMSTF guidelines, an advanced adenoma does not mandate 5-year follow-ups indefinitely – after 2 colonoscopies with low-risk findings, the patient’s risk returns to near baseline, and her next surveillance interval can stretch up to 10 years.
- Due to the initial high-risk adenoma, screening with FIT testing is not recommended – CSCOPE Only









